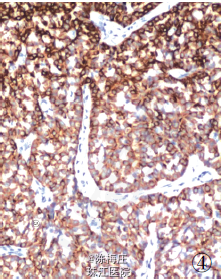

打开应用乳腺神经内分泌癌伴结肠腺癌及卵巢Brenner 瘤
妇产科
陈医师

南方医科大学珠江医院
主诉 病史
患者,62 岁,因发现右乳肿物1 年,腹痛、腹胀20 天伴血便入院。
查体 复查
查体:乳腺右侧外上象限触及一直径约4 cm 肿物,质硬,活动,与周围界较清;左侧盆腔包块,直径约11cm。
影像学检查:钼靶显示右乳腺浅分叶状高密度影,边界尚清,无钙化及毛刺征;CT 平扫盆腔类圆形实性肿块影,边界清晰,瘤体内见不定形钙化,结肠部分肠腔狭窄,肠壁增厚;遂行结肠镜检查示乙状结肠可见肿物,覆脓苔,质脆。血清中CEA 70.23 ug/ ml、CA125422.15 KU/ L,CA199 137.53 U/ml。
诊断 治疗
最后诊断:右乳神经内分泌癌;结肠腺癌;左侧卵巢Brenner 瘤。
遂行右乳肿物切除术+ 乙状结肠癌切除术及左侧附件切除术。术中所见:右乳肿物分叶状,与周围界清;乙状结肠肿物与周围无粘连;左侧卵巢肿物包膜完整,未见腹水。术后病理显示右乳腺内分泌癌,乙状结肠腺癌,左侧卵巢Brenner 瘤。

随访 处理
本例患者同时发生乳腺神经内分泌癌和结肠腺癌,属于重复癌,又称多原发癌,指同一患者体内单个或多个器官同时或先后发生逸2 种的原发性恶性肿瘤[13] 。重复癌的发生与遗传因素、不良生活方式、免疫力低下等密切相关。本例患者同时伴发卵巢Brenner 瘤,国内外均未见报道。患者经手术切除+ 术后化疗,术后随访3 个月,未见肿瘤复发及转移,目前仍在随访中。doi:10. 13315/ j. cnki. cjcep. 2014. 09. 037
相似病例推荐
乳腺神经内分泌癌1例汇报
2017-04-20阅读量:5820
结肠大细胞神经内分泌癌和低分化腺癌
2015-08-09阅读量:5682
乳腺神经内分泌癌伴结肠腺癌及卵巢 Brenner 瘤 1 例
2015-01-08阅读量:4773

共5评论最早评论
方超
四川大学华西医院
这个确实了……有时候真的是命啊
2015-07-14 19:59
张竹萍
吉林大学第二医院
…重复癌比较少见了。还是转移性的肿瘤要常见一些。不知道这有什么病因引起这种情况呢?有明确家族史吗?
2015-07-14 20:52
周青
广西医科大学附属肿瘤医院
感谢楼主的精彩病例,学习了。不知该患者重复癌术后的化疗方案是如何考虑与制定的呢?
2015-07-15 09:20
高长军
公主岭守安医院
学习了,谢谢分享
2017-01-20 21:43
王娟
潍坊市坊子区人民医院
学习
2017-12-05 08:55
没有更多数据了